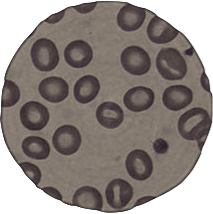
Leeuwenhoek, Malpighi y Swammerdan, describen las células sanguíneas.
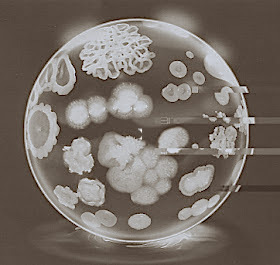
Cagniard-Latour, relación entre fermentación y seres vivos.

-
 No se tiene certeza si lo inventó primero el biólogo y genetista Lippershey o el fabricante de lentes Janssen, pero su invento llevó a que los descubrimientos científicos sobre los microorganismos dieran un gran avance.
No se tiene certeza si lo inventó primero el biólogo y genetista Lippershey o el fabricante de lentes Janssen, pero su invento llevó a que los descubrimientos científicos sobre los microorganismos dieran un gran avance. -
 Físico y astrónomo inglés, el cual detalló sus observaciones microscópicas, nombrando por primera vez la “célula” como pequeñas cavidades poliédricas, parecidas a la forma de un panal.
Físico y astrónomo inglés, el cual detalló sus observaciones microscópicas, nombrando por primera vez la “célula” como pequeñas cavidades poliédricas, parecidas a la forma de un panal. -
 Anatomista y biólogo que llevó a cabo la primera observación microscópica sobre la anatomía de las plantas.
Anatomista y biólogo que llevó a cabo la primera observación microscópica sobre la anatomía de las plantas. -
 Biólogo neerlandés, que gracias a su microscopio más avanzados logró observar por primera vez lo que él llamaría como “animálculos”, conocido actualmente como protozoos y bacterias.
Biólogo neerlandés, que gracias a su microscopio más avanzados logró observar por primera vez lo que él llamaría como “animálculos”, conocido actualmente como protozoos y bacterias. -
 Este médico, especialista en fisiología y anatomía afirmó que los tejidos vegetales estaban constituidos por células.
Este médico, especialista en fisiología y anatomía afirmó que los tejidos vegetales estaban constituidos por células. -
Estos biólogos y anatomistas lograron mediante investigaciones independientes describir los corpúsculos presentes en la sangre.
Estos biólogos y anatomistas lograron mediante investigaciones independientes describir los corpúsculos presentes en la sangre. -
 Naturalista que descubrió un proceso relevante en la vida celular.
Naturalista que descubrió un proceso relevante en la vida celular. -
 Este microscopista sin saber que era y sin darle un nombre logra identificar por primera vez el organelo que más tarde se nombrará “Núcleo”.
Este microscopista sin saber que era y sin darle un nombre logra identificar por primera vez el organelo que más tarde se nombrará “Núcleo”. -
 Este médico, biólogo y fisiólogo da a entender que todos los organismos están creados a base de “células”.
Este médico, biólogo y fisiólogo da a entender que todos los organismos están creados a base de “células”. -
 El anatomista confirma que los tejidos animales y vegetales están compuestos de células.
El anatomista confirma que los tejidos animales y vegetales están compuestos de células. -
 Medio cirujano que logra observar e identificar un organelo en el interior de las células que denomina "núcleo".
Medio cirujano que logra observar e identificar un organelo en el interior de las células que denomina "núcleo". -
 Briólogo, que logró describir la división binaria de las células vegetales, provocando que otras teorías se rechacen.
Briólogo, que logró describir la división binaria de las células vegetales, provocando que otras teorías se rechacen. -
 Este médico hizo posible que se le diera tal nombre a la materia existe de toda la célula.
Este médico hizo posible que se le diera tal nombre a la materia existe de toda la célula. -
Físico que concluyó que la fermentación tiene relación con los seres vivos
Físico que concluyó que la fermentación tiene relación con los seres vivos -
 Este botánico y este fisiólogo postularon y llevaron a cabo la teoría celular.
Este botánico y este fisiólogo postularon y llevaron a cabo la teoría celular. -
 Anatomista, embriólogo, fisiólogo, zoólogo y botánico fue el primero en investigar y descubrir información sobre el proceso de Espermatogénesis.
Anatomista, embriólogo, fisiólogo, zoólogo y botánico fue el primero en investigar y descubrir información sobre el proceso de Espermatogénesis. -
 Químico, físico, matemático y bacteriólogo descubre que la fermentación es causada por microorganismos.
Químico, físico, matemático y bacteriólogo descubre que la fermentación es causada por microorganismos. -
 Algologista y político que descubrió el proceso de fecundación en las algas.
Algologista y político que descubrió el proceso de fecundación en las algas. -
 Anatomista, embriólogo, fisiólogo, zoólogo y botánico que descubrió y observó por primera vez a la mitocondria.
Anatomista, embriólogo, fisiólogo, zoólogo y botánico que descubrió y observó por primera vez a la mitocondria. -
 Médico patólogo, antropólogo, político y biólogo, que desarrolla la teoría celular gracias a su conclusión de que la célula proviene de otra célula ("Célula a Célula”).
Médico patólogo, antropólogo, político y biólogo, que desarrolla la teoría celular gracias a su conclusión de que la célula proviene de otra célula ("Célula a Célula”). -
 Este biólogo y naturalista lleva a cabo sus experimentos sobre la reproducción de los guisantes que muestran cómo características físicas tales como la estatura y el color se transmiten de una generación a la siguiente a través de genes.
Este biólogo y naturalista lleva a cabo sus experimentos sobre la reproducción de los guisantes que muestran cómo características físicas tales como la estatura y el color se transmiten de una generación a la siguiente a través de genes. -
 Biólogo y médico que aisló núcleos a partir del pus de vendajes quirúrgicos y comprobó que estaban formados por una única sustancia química que denominó NUCLEÍNA («ácido nucleico»).
Biólogo y médico que aisló núcleos a partir del pus de vendajes quirúrgicos y comprobó que estaban formados por una única sustancia química que denominó NUCLEÍNA («ácido nucleico»). -
 Médico y profesor de anatomía que logró visualizar los cromosomas en división, esto le permitió describir la manera en que se replican los cromosomas «la mitosis».
Médico y profesor de anatomía que logró visualizar los cromosomas en división, esto le permitió describir la manera en que se replican los cromosomas «la mitosis». -
 Este analista y patólogo nombró a los cromosomas.
Este analista y patólogo nombró a los cromosomas. -
 Llego a descifrar los componentes químicos de la nucleína, además de demostrar que había proteínas presentes en ella, las cuáles son sustancias básicas ricas en nitrógeno y que contienen un glúcido de cinco átomos de carbono.
Llego a descifrar los componentes químicos de la nucleína, además de demostrar que había proteínas presentes en ella, las cuáles son sustancias básicas ricas en nitrógeno y que contienen un glúcido de cinco átomos de carbono. -
 El patólogo e histólogo Altman utiliza técnicas fisicoquímicas para describir la nucleína , debido a sus características acuñe el término de «ácido nucleico» y los describe como «sustancias ricas en fósforo localizadas exclusivamente en el núcleo celular».
El patólogo e histólogo Altman utiliza técnicas fisicoquímicas para describir la nucleína , debido a sus características acuñe el término de «ácido nucleico» y los describe como «sustancias ricas en fósforo localizadas exclusivamente en el núcleo celular». -
 Biólogo que desarrolló la teoría del plasma germinal el cual permite que se cumpla la herencia.
Biólogo que desarrolló la teoría del plasma germinal el cual permite que se cumpla la herencia. -
 Este médico y científico dió a conocer su propia teoría sobre el funcionamiento y definición de la neurona, en la cual se dice que estas son informantes del sistema.
Este médico y científico dió a conocer su propia teoría sobre el funcionamiento y definición de la neurona, en la cual se dice que estas son informantes del sistema. -
 El médico y genetista Walter realizó una serie de experimentos que le permitieron proponer que los genes de Mendel son unidades físicas que realmente se localizan en los cromosomas y junto con el embriólogo Boveri descubrieron la «Meiosis».
El médico y genetista Walter realizó una serie de experimentos que le permitieron proponer que los genes de Mendel son unidades físicas que realmente se localizan en los cromosomas y junto con el embriólogo Boveri descubrieron la «Meiosis». -
 El biólogo y genetista Bateson acuñó el término «genética» para designar "la ciencia dedicada al estudio de los fenómenos de la herencia y de la variación", también introdujo los términos alelomorfo, cigoto, homocigoto y heterocigoto.
El biólogo y genetista Bateson acuñó el término «genética» para designar "la ciencia dedicada al estudio de los fenómenos de la herencia y de la variación", también introdujo los términos alelomorfo, cigoto, homocigoto y heterocigoto. -
 Este doctor y bioquímico manifesto que los ác. nucleicos estaban compuestos de ác. fosfórico, una pentosa y las bases nitrogenadas (esqueleto Azúcar-Base Nitrogenada). Demostró la existencia de 2 tipos de ác. nucleicos: uno de tipo azúcar (D-ribonse) y los derivados de L-deoxy llamado desoxirribosa
Este doctor y bioquímico manifesto que los ác. nucleicos estaban compuestos de ác. fosfórico, una pentosa y las bases nitrogenadas (esqueleto Azúcar-Base Nitrogenada). Demostró la existencia de 2 tipos de ác. nucleicos: uno de tipo azúcar (D-ribonse) y los derivados de L-deoxy llamado desoxirribosa -
 Este genetista reconoció la presencia de los cromosomas sexuales. Sus experimentos revelaron la base genética de la determinación del sexo. Demostró que los cromosomas son portadores de los genes y que los genes se disponen de forma lineal sobre los cromosomas, en su "Teoría de los genes" demostró que los mismos se encuentran unidos en diferentes grupos de encadenamiento, y que los alelos (pares de genes que afectan al mismo carácter) se intercambian o entrecruzan dentro del mismo grupo.
Este genetista reconoció la presencia de los cromosomas sexuales. Sus experimentos revelaron la base genética de la determinación del sexo. Demostró que los cromosomas son portadores de los genes y que los genes se disponen de forma lineal sobre los cromosomas, en su "Teoría de los genes" demostró que los mismos se encuentran unidos en diferentes grupos de encadenamiento, y que los alelos (pares de genes que afectan al mismo carácter) se intercambian o entrecruzan dentro del mismo grupo. -
 Estos biólogos y genetistas demostraron que la radiación X inducía mutaciones en los genes
Estos biólogos y genetistas demostraron que la radiación X inducía mutaciones en los genes -
 Levene demostró a través de una larga observación, que la pentosa que aparece en la nucleína de levadura era ribosa, pero espero, hasta poder identificarlo como desoxirribosa.
Levene demostró a través de una larga observación, que la pentosa que aparece en la nucleína de levadura era ribosa, pero espero, hasta poder identificarlo como desoxirribosa. -
 Biólogo que determinó que el núcleo produce una sustancia que dirige o controla las características de la célula (material genético), y por lo tanto, influye en el desarrollo del organismo.
Biólogo que determinó que el núcleo produce una sustancia que dirige o controla las características de la célula (material genético), y por lo tanto, influye en el desarrollo del organismo. -
 Físico y biólogo que produjo el primer patrón que mostraba que el DNA tenía una estructura regular (espacio de 0,33 nm a lo largo del ADN) a través de difracción de rayos X. Fue el primer científico en denominarse «Biólogo Molecular»
Físico y biólogo que produjo el primer patrón que mostraba que el DNA tenía una estructura regular (espacio de 0,33 nm a lo largo del ADN) a través de difracción de rayos X. Fue el primer científico en denominarse «Biólogo Molecular» -
 Biólogo e informatologo que acuñó el término de «Biología Molecular»
Biólogo e informatologo que acuñó el término de «Biología Molecular» -
 Demostraron que las mutaciones que permitían a la bacteria E. coli resistir la infección por el virus bacteriófago T1 existían de manera previa a la exposición de la bacteria a este agente infeccioso y que, por tanto, dichas mutaciones no eran inducidas por la presencia de este sino que se generaban de manera aleatoria. También pudieron demostrar que dichas mutaciones, se traspasaron a las siguientes generaciones, permitiendo la evolución de la especie.
Demostraron que las mutaciones que permitían a la bacteria E. coli resistir la infección por el virus bacteriófago T1 existían de manera previa a la exposición de la bacteria a este agente infeccioso y que, por tanto, dichas mutaciones no eran inducidas por la presencia de este sino que se generaban de manera aleatoria. También pudieron demostrar que dichas mutaciones, se traspasaron a las siguientes generaciones, permitiendo la evolución de la especie. -
 El médico e investigador junto a los genetistas intentan desentrañar la naturaleza del material genético demostraron que las cepas avirulentas de Griffith se transformaban en virulentas con la exposición al ADN, pero no a las proteínas. También aportan la primera prueba experimental de que el ADN transmite la información genética.
El médico e investigador junto a los genetistas intentan desentrañar la naturaleza del material genético demostraron que las cepas avirulentas de Griffith se transformaban en virulentas con la exposición al ADN, pero no a las proteínas. También aportan la primera prueba experimental de que el ADN transmite la información genética. -
 El físico E. Chargaff, publica sus observaciones acerca de la composición de bases del ADN, donde se basa en la relación cuantitativa de los nucleótidos que forman la doble hélice del ADN
El físico E. Chargaff, publica sus observaciones acerca de la composición de bases del ADN, donde se basa en la relación cuantitativa de los nucleótidos que forman la doble hélice del ADN -
 Demostró que la síntesis de proteínas ocurría en unas partículas intracelulares compuestas de ácido ribonucleico y proteínas, por lo que posteriormente fueron denominadas como ribosomas.
Demostró que la síntesis de proteínas ocurría en unas partículas intracelulares compuestas de ácido ribonucleico y proteínas, por lo que posteriormente fueron denominadas como ribosomas. -
 Los bioquímicos A. Hershey y M.Chase con sus trabajos sobre el fago T2 apoya la tesis del ADN como material genético
Los bioquímicos A. Hershey y M.Chase con sus trabajos sobre el fago T2 apoya la tesis del ADN como material genético -
 Estos biólogos propusieron el modelo de la doble hélice de ADN para representar la estructura tridimensional del polímero.
Estos biólogos propusieron el modelo de la doble hélice de ADN para representar la estructura tridimensional del polímero. -
 Química que en colaboración con su discípulo Gossling consigue, con el difractómetro de rayos X, fotografiar la cara B del ADN hidratado, la famosa Foto 51, columna vertebral del ADN.
Química que en colaboración con su discípulo Gossling consigue, con el difractómetro de rayos X, fotografiar la cara B del ADN hidratado, la famosa Foto 51, columna vertebral del ADN. -
 Físico y biólogo que anuncia el dogma central de la Biología Molecular; Replicación, Transcripción y Traducción.
Físico y biólogo que anuncia el dogma central de la Biología Molecular; Replicación, Transcripción y Traducción. -
 Expertos en el área de la biología molecular investigaron el proceso de replicación de ADN, descubriendo así que esta era semiconservadora.
Expertos en el área de la biología molecular investigaron el proceso de replicación de ADN, descubriendo así que esta era semiconservadora. -
 Profesor gestor de la creación de la primera carrera universitaria sobre bioquímica en Chile, perteneciente a la Universidad de Chile.
Profesor gestor de la creación de la primera carrera universitaria sobre bioquímica en Chile, perteneciente a la Universidad de Chile. -
 El biólogo Gurdon logró determinar que el núcleo de las células contiene todo lo necesario para formar a un organismo completo, logrando replicar a una rana africana completa, procedimiento al cual llamó clonación.
El biólogo Gurdon logró determinar que el núcleo de las células contiene todo lo necesario para formar a un organismo completo, logrando replicar a una rana africana completa, procedimiento al cual llamó clonación. -
 Descifran el código genético que utilizan todas las células vivas para traducir la serie de tripletes (codones) que hay en las bases de su ADN en instrucciones para la producción de proteínas.
Descifran el código genético que utilizan todas las células vivas para traducir la serie de tripletes (codones) que hay en las bases de su ADN en instrucciones para la producción de proteínas. -
 Biólogo que descubrió la primera enzima de restricción lo cual le permitió obtener fragmentos genéticamente activos tras la separación controlada de genes.
Biólogo que descubrió la primera enzima de restricción lo cual le permitió obtener fragmentos genéticamente activos tras la separación controlada de genes. -
 El genetista junto al biólogo descubrieron una actividad catalítica que denominaron transcriptasa inversa o «retrotranscriptasa»
El genetista junto al biólogo descubrieron una actividad catalítica que denominaron transcriptasa inversa o «retrotranscriptasa» -
 El bioquímico y genetista fueron los primeros en lograr la clonación de un gen
El bioquímico y genetista fueron los primeros en lograr la clonación de un gen -
 Los doctores Niemeyer, Perreta, Clark, Beytia, Foradori y Yudelevich lograron llevar a cabo la “Sociedad de Bioquímica y Biología Molecular de Chile” (SBBM) mediante un documento jurídico.
Los doctores Niemeyer, Perreta, Clark, Beytia, Foradori y Yudelevich lograron llevar a cabo la “Sociedad de Bioquímica y Biología Molecular de Chile” (SBBM) mediante un documento jurídico. -
 El biólogo molecular desarrolla un método conocido como Southern Blott para identificar una secuencia genética específica.
El biólogo molecular desarrolla un método conocido como Southern Blott para identificar una secuencia genética específica. -
 Diversos doctores de la SBBM descubren la cinética sigmoidal de las proteínas monoméricas.
Diversos doctores de la SBBM descubren la cinética sigmoidal de las proteínas monoméricas. -
 Llevaron a cabo métodos para "descifrar" de una manera más rápida secciones largas de ADN gracias a la determinación de la secuencia de las bases.
Llevaron a cabo métodos para "descifrar" de una manera más rápida secciones largas de ADN gracias a la determinación de la secuencia de las bases. -
 Se lleva a cabo la 1era reunión anual de la “Sociedad de Bioquímica y Biología Molecular de Chile”
Se lleva a cabo la 1era reunión anual de la “Sociedad de Bioquímica y Biología Molecular de Chile” -
 Genetista y hematólogo junto a la médica descubren los polimorfismos de longitud de fragmento de restricción (RFLP) los cuáles se utilizan como marcadores en los mapas genéticos y para visualizarlos se utiliza la electroforesis en gel.
Genetista y hematólogo junto a la médica descubren los polimorfismos de longitud de fragmento de restricción (RFLP) los cuáles se utilizan como marcadores en los mapas genéticos y para visualizarlos se utiliza la electroforesis en gel. -
 Bioquímico que describe el primer ribosoma: la RNasa P.
Bioquímico que describe el primer ribosoma: la RNasa P. -
 Bioquímico que desarrolló el método para sintetizar insulina humana usando tecnología de ADN recombinante.
Bioquímico que desarrolló el método para sintetizar insulina humana usando tecnología de ADN recombinante. -
 Profesor de neurologías y bioquímica que descubre que los priones son partículas infecciosas compuestas sólo por proteínas, sin ácidos nucleicos.
Profesor de neurologías y bioquímica que descubre que los priones son partículas infecciosas compuestas sólo por proteínas, sin ácidos nucleicos. -
 Bioquímico que desarrolla el método de la reacción en cadena de polimerasa (PCR), que permite detectar rápidamente una secuencia de ADN específica.
Bioquímico que desarrolla el método de la reacción en cadena de polimerasa (PCR), que permite detectar rápidamente una secuencia de ADN específica. -
 Genetistas moleculares desarrollan la electroforesis en campo pulsante para separar moléculas de DNA de alto peso molecular.
Genetistas moleculares desarrollan la electroforesis en campo pulsante para separar moléculas de DNA de alto peso molecular. -
 El genetista desarrolla las huellas genómicas (genome fingerprintings) digiriendo ADN con enzimas de restricción e hibridándolo con sondas radiactivas para caracterizar e identificar individuos.
El genetista desarrolla las huellas genómicas (genome fingerprintings) digiriendo ADN con enzimas de restricción e hibridándolo con sondas radiactivas para caracterizar e identificar individuos. -
 La creación de este bioquímico fue muy relevante a nivel mundial, ya que este creó la primera vacuna recombinante que tiene como objetivo combatir la hepatitis.
La creación de este bioquímico fue muy relevante a nivel mundial, ya que este creó la primera vacuna recombinante que tiene como objetivo combatir la hepatitis. -
 El 1 de octubre de 1990 se le da inicio a uno de los proyectos internacionales más importantes sobre los genomas humanos.
El 1 de octubre de 1990 se le da inicio a uno de los proyectos internacionales más importantes sobre los genomas humanos. -
 Embriólogo que consiguió el primer organismo superior clonado, y demostrando que pueden seguir reproduciéndose de la manera natural.
Embriólogo que consiguió el primer organismo superior clonado, y demostrando que pueden seguir reproduciéndose de la manera natural. -
 Especialista en Infectología forma parte sobre el estudio de “Ecología y enfermedad por hantavirus en Chile”.
Especialista en Infectología forma parte sobre el estudio de “Ecología y enfermedad por hantavirus en Chile”. -
 El Inmunólogo Rosemblatt junto a la dra Bono, llevaron a cabo el proyecto titulado: “Mecanismos que regulan la expresión de receptores de Homing en linfocitos T”
El Inmunólogo Rosemblatt junto a la dra Bono, llevaron a cabo el proyecto titulado: “Mecanismos que regulan la expresión de receptores de Homing en linfocitos T” -
 El 14 de abril del 2003 se le dió fin al proyecto sobre la investigación de los genomas humanos. Siendo esta una de las investigaciones más grandes en las ciencias de todo el mundo.
El 14 de abril del 2003 se le dió fin al proyecto sobre la investigación de los genomas humanos. Siendo esta una de las investigaciones más grandes en las ciencias de todo el mundo. -
 Los doctores Burzio y Villegas junto a la bioquímica Burzio hicieron el hallazgo de RNAs no codificadores mitocondriales, lo cual permitió la regulación de la proliferación celular y además logró ser beneficiaria para el tratamiento contra en cáncer.
Los doctores Burzio y Villegas junto a la bioquímica Burzio hicieron el hallazgo de RNAs no codificadores mitocondriales, lo cual permitió la regulación de la proliferación celular y además logró ser beneficiaria para el tratamiento contra en cáncer. -
 Especialista en Epidemiología e Infectología que expanden la investigación que inició en 1999, cambiando a “Ecología y enfermedad por hantavirus en Chile y Panamá”
Especialista en Epidemiología e Infectología que expanden la investigación que inició en 1999, cambiando a “Ecología y enfermedad por hantavirus en Chile y Panamá” -
 La dra Bono junto al Inmunólogo Rosemblatt, desarrollaron la investigación titulada; “Modulación del Homing en el Sistema Inmune”
La dra Bono junto al Inmunólogo Rosemblatt, desarrollaron la investigación titulada; “Modulación del Homing en el Sistema Inmune” -
 El Inmunólogo Rosemblatt y la dra Bono, desarrollaron el proyecto titulado: “Microambiente linfoide y polarización de la respuesta inmune”
El Inmunólogo Rosemblatt y la dra Bono, desarrollaron el proyecto titulado: “Microambiente linfoide y polarización de la respuesta inmune” -
 Biólogo junto al investigador médico Realizaron una investigación, en la que, insertaron cuatro factores de transcripción en las células de la piel de ratones se transformandolas a células madre como las embrionarias. Y tiempo después se demostró que esas células son capaces de transformarse en diferentes tipos de tejidos.
Biólogo junto al investigador médico Realizaron una investigación, en la que, insertaron cuatro factores de transcripción en las células de la piel de ratones se transformandolas a células madre como las embrionarias. Y tiempo después se demostró que esas células son capaces de transformarse en diferentes tipos de tejidos. -
 Especialista en Infectología Pediátrica que participa en la investigación sobre la Caracterización genética y la coevolución huésped-viral en roedores chilenos infectados por hantavirus.
Especialista en Infectología Pediátrica que participa en la investigación sobre la Caracterización genética y la coevolución huésped-viral en roedores chilenos infectados por hantavirus. -
 Biólogo que reconstruyó los 381 genes de la bacteria Mycoplasma genitalium. El resultado es una sucesión de 580.000 letras químicas (codifican la información que hace que la bacteria se reproduzca o crezca).
Biólogo que reconstruyó los 381 genes de la bacteria Mycoplasma genitalium. El resultado es una sucesión de 580.000 letras químicas (codifican la información que hace que la bacteria se reproduzca o crezca). -
 Especialista en ecología, química biológica, biología celular y entomología que realizó una investigación que busca desarrollar tecnologías para la obtención y potencial uso de células troncales mesenquimáticas desde gelatina de wharton para el tratamiento de lesiones vasculares causadas por isquemia crónica de las extremidades.
Especialista en ecología, química biológica, biología celular y entomología que realizó una investigación que busca desarrollar tecnologías para la obtención y potencial uso de células troncales mesenquimáticas desde gelatina de wharton para el tratamiento de lesiones vasculares causadas por isquemia crónica de las extremidades. -
 Especialista en infectología y bioquímico que participaron en el estudio nombrado “Transmisión y patogenia del virus de los Andes en Chile”.
Especialista en infectología y bioquímico que participaron en el estudio nombrado “Transmisión y patogenia del virus de los Andes en Chile”. -
 Los inmunólogos llevaron a cabo un nuevo proyecto que busca la Reprogramación de células T reguladoras en la inmunidad intestinal.
Los inmunólogos llevaron a cabo un nuevo proyecto que busca la Reprogramación de células T reguladoras en la inmunidad intestinal. -
 Bioquímicos que desarrollaron el primer anticuerpo quimérico que va en contra del factor de necrosis tumoral humano.
Bioquímicos que desarrollaron el primer anticuerpo quimérico que va en contra del factor de necrosis tumoral humano. -
 Varios especialistas del área de la biología de la UCH realizaron un mejoramiento de las capacidades de la Unidad de Microscopía Avanzada.
Varios especialistas del área de la biología de la UCH realizaron un mejoramiento de las capacidades de la Unidad de Microscopía Avanzada. -
 Nuevas tecnología CRISPR/Cas9 que permite modificar el genoma de cualquier célula.
Nuevas tecnología CRISPR/Cas9 que permite modificar el genoma de cualquier célula. -
 Inmunólogo que consiguió un antídoto que fue patentado en Chile, Estados Unidos, India, China y la Comunidad Europea. Esto llevó a que se convirtiera en el 1er estudio clínico chileno de una vacuna desarrollada bajo las reglas de la FDA y con la aprobación del Instituto de Salud Pública.
Inmunólogo que consiguió un antídoto que fue patentado en Chile, Estados Unidos, India, China y la Comunidad Europea. Esto llevó a que se convirtiera en el 1er estudio clínico chileno de una vacuna desarrollada bajo las reglas de la FDA y con la aprobación del Instituto de Salud Pública. -
 Especialista en infectología y bioquímico llevaron a cabo la investigación nombrada: “Patogénesis molecular de virus emergentes”
Especialista en infectología y bioquímico llevaron a cabo la investigación nombrada: “Patogénesis molecular de virus emergentes” -
 Inmunológas que realizaron el proyecto en base a la sinapsis de células B en enfermedades autoinmunes.
Inmunológas que realizaron el proyecto en base a la sinapsis de células B en enfermedades autoinmunes. -
 Las dos especialistas en inmunología realizan la investigación titulada: “Papel de los macrófagos en el lupus eritematoso sistémico”.
Las dos especialistas en inmunología realizan la investigación titulada: “Papel de los macrófagos en el lupus eritematoso sistémico”. -
 Bioquímicos que crearon el primer biosimilar el cual es un anticuerpo quimérico contra el marcador CD20, con utilidad en el tratamiento del linfoma no Hodgkin y autoinmunidad.
Bioquímicos que crearon el primer biosimilar el cual es un anticuerpo quimérico contra el marcador CD20, con utilidad en el tratamiento del linfoma no Hodgkin y autoinmunidad. -
 Gracias al PrimPol (recientemente descubierto) se puede reiniciar la replicación de ADNmt estancado y puede estimular la replicación de ADNmt.
Gracias al PrimPol (recientemente descubierto) se puede reiniciar la replicación de ADNmt estancado y puede estimular la replicación de ADNmt. -
 Experta en Epidemiología e Infectología que participa en el estudio sobre la “Comprensión de la respuesta del huésped al enfoque inmunológico y transcriptómico de ANDV”
Experta en Epidemiología e Infectología que participa en el estudio sobre la “Comprensión de la respuesta del huésped al enfoque inmunológico y transcriptómico de ANDV” -
 Especialista en Infectología Pediátrica que da inicio a uno de sus primeros proyectos sobre el hantavirus; “Cuasiespecies virales, inmunidad del hospedador oral y factores constitutivos en casos infectados por ANDV y sujetos expuestos: rol en la infección y transmisión”
Especialista en Infectología Pediátrica que da inicio a uno de sus primeros proyectos sobre el hantavirus; “Cuasiespecies virales, inmunidad del hospedador oral y factores constitutivos en casos infectados por ANDV y sujetos expuestos: rol en la infección y transmisión” -
 Se presenta una versión más precisa de la herramienta de edición de ADN, CRISPR 2.0.
Se presenta una versión más precisa de la herramienta de edición de ADN, CRISPR 2.0. -
 La mencionada en Biología Molecular, Celular y Neurociencia junto a los inmunólogos dieron inicio a la investigación sobre la producción de adenosina mediada por CD73 en el control de la diferenciación de células T CD8 +.
La mencionada en Biología Molecular, Celular y Neurociencia junto a los inmunólogos dieron inicio a la investigación sobre la producción de adenosina mediada por CD73 en el control de la diferenciación de células T CD8 +. -
 Se crean las vacunas contra el COVID-19, las cuales combaten el virus mediante el uso del ARN mensajero.
Se crean las vacunas contra el COVID-19, las cuales combaten el virus mediante el uso del ARN mensajero. -
 Biólogos e inmunólogos llevan a cabo el proyecto que tiene como tema lo siguiente: “Insuficiencia hepática aguda o crónica: reversión mediante la administración sistémica de células madre mesenquimales derivadas de esferoides 3D”.
Biólogos e inmunólogos llevan a cabo el proyecto que tiene como tema lo siguiente: “Insuficiencia hepática aguda o crónica: reversión mediante la administración sistémica de células madre mesenquimales derivadas de esferoides 3D”.
Plan projects on a visual timeline
Map milestones, phases, deadlines, and key events in one place so the sequence is easier to see and share. Timetoast is a timeline maker for work, school, research, and stories.
